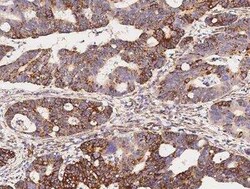
COX4-I1 Antibody, Novus Biologicals 50 &mu;g; Unconjugated:Anticorps, Polyclonal

missing translation for 'onlineSavingsMsg'
Learn More
Learn More
COX4-I1 Antibody, Novus Biologicals™
Rabbit Polyclonal Antibody
Marque: Novus Biologicals NBP3-05850-50ul
Les retours ne sont pas autorisés pour ce produit.
Afficher la politique du retour.
Description
COX4-I1 Polyclonal antibody specifically detects COX4-I1 in Human samples. It is validated for Immunohistochemistry (Paraffin)
Spécification
| COX4-I1 | |
| Polyclonal | |
| Immunohistochemistry-Paraffin 1:500-1:2000 | |
| Rabbit | |
| Antigen and protein A Affinity-purified | |
| RUO | |
| Human | |
| Purified |
| Immunohistochemistry (Paraffin) | |
| Unconjugated | |
| 0.2 um filtered solution in PBS | |
| Produced in rabbits immunized with a synthetic peptide corresponding to the C-terminus of the Human COX4-I1. | |
| 50 μg | |
| Primary | |
| Store at 4°C short term. Aliquot and store at -20°C long term. Avoid freeze-thaw cycles. | |
| IgG |
Correction du contenu d'un produit
Veuillez fournir vos retours sur le contenu du produit en remplissant le formulaire ci-dessous.
Nom du produit
Vous avez repéré une opportunité d'amélioration ?Partager une correction de contenu